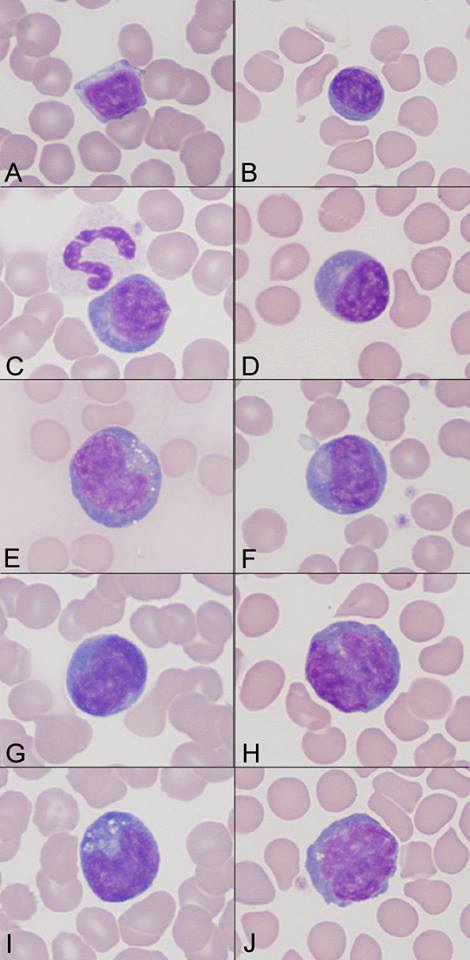

Lymphocyte:
- A: Normal small, mature lymphocyte.
- B: Small “plasmacytoid” lymphocyte: this cell has increased amounts of darker blue cytoplasm than normal.
- C: Another variant of a “plasmacytoid” lymphocyte. The adjacent neutrophil indicates the lymphocyte is small.
- D: Another variant of a “plasmacytoid” lymphocyte with more abundant cytoplasm and a perinuclear clear zone.
- E: A large reactive lymphocyte. This cell has cytoplasmic vacuoles, medium blue cytoplasm, but a coarse chromatin with no nucleoli.
- F: A larger “plasmacytoid” lymphocyte.
- G: Large reactive lymphocyte with a pleomorphic nucleus and smooth dark blue cytoplasm.
- H: Large reactive lymphocyte with “bi-lobed” nucleus.
- I: Large reactive lymphocyte with pleomorphic nucleus, deep blue cytoplasm and cytoplasmic vacuoles.
- J: Another variant of a large reactive lymphocyte with a pleomorphic nucleus.